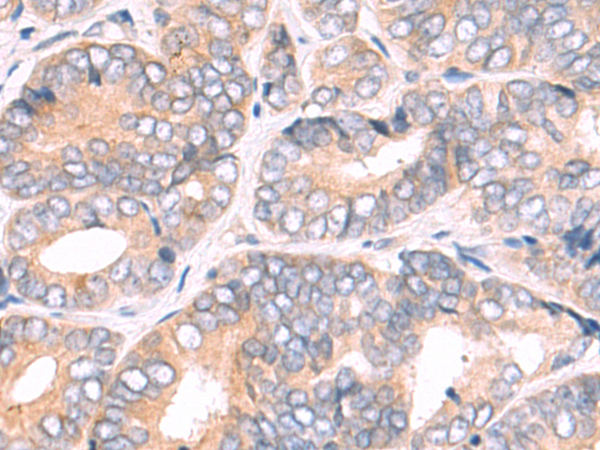
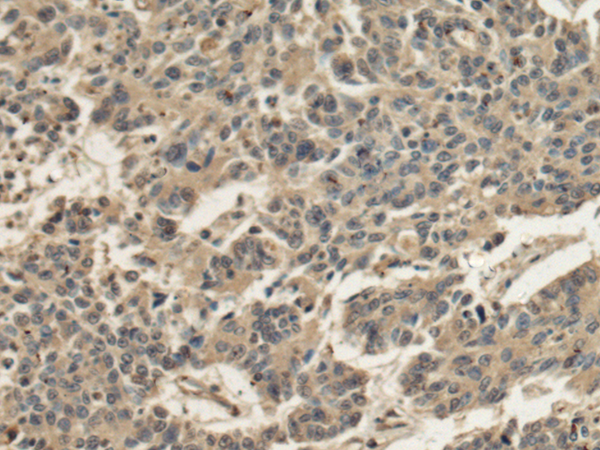
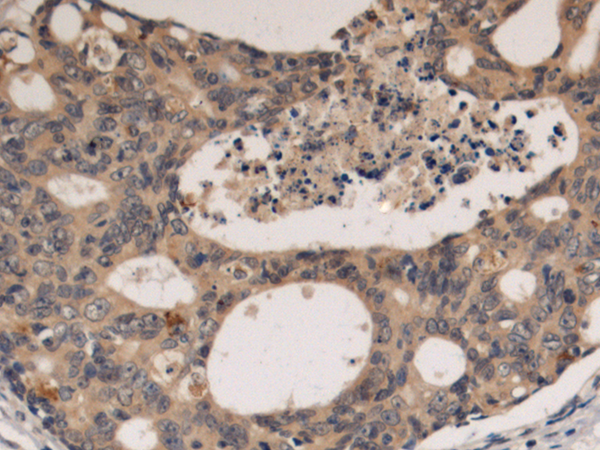
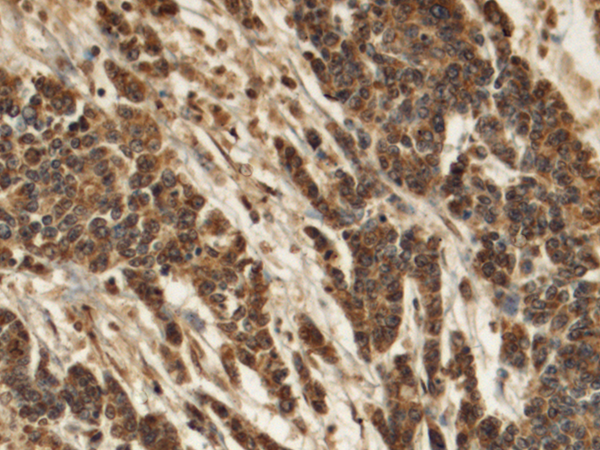
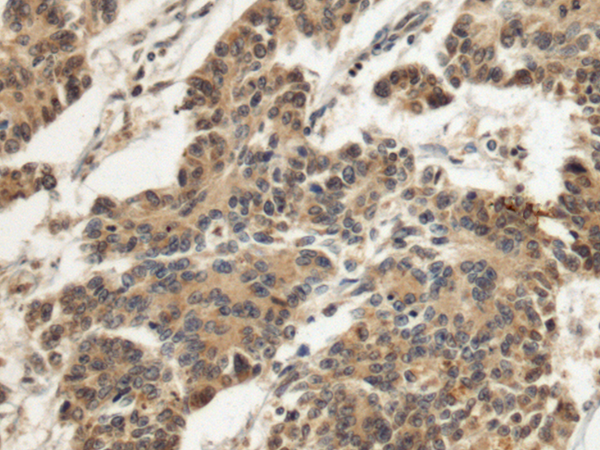

-
分类: 科研抗体货号: P10504别名: AKU; HGO应用: WB,IHC反应种属: Human, Mouse
-
分类: 科研抗体货号: P10464别名: MRX74; dJ1158H2.1应用: IHC反应种属: Human
-
分类: 科研抗体货号: P10483别名:应用: IHC反应种属: Human, Mouse, Rat
-
分类: 科研抗体货号: P10503别名: HEED; COGIS; WAIT1应用: WB反应种属: Human, Mouse
-
分类: 科研抗体货号: P10463别名: BH; EMAP; ELP79; EMAPL; HuEMAP应用: IHC反应种属: Human, Mouse, Rat
-
分类: 科研抗体货号: P10482别名: P28; hp28; dJ423B22.5应用: WB,IHC反应种属: Human, Mouse, Rat
-
分类: 科研抗体货号: P10502别名: dJ126A5.1应用: WB,IHC反应种属: Human, Mouse
-
分类: 科研抗体货号: P10491别名: FARS1; PheRS; SPG77; COXPD14; HSPC320; mtPheRS应用: WB,IHC反应种属: Human, Mouse
-
分类: 科研抗体货号: P10481别名: GAN1; KLHL16应用: WB,IHC反应种属: Human, Mouse
-
分类: 科研抗体货号: P10501别名: 6530404F10Rik应用: IHC反应种属: Human

鄂公网安备42018502007531号
鄂公网安备42018502007531号

